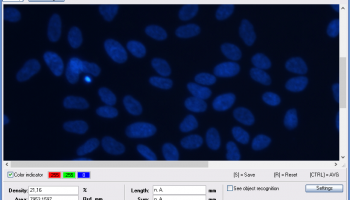
GSA Image Analyser screenshot

Popular x64 Tags
- image x64 download
- design x64 download
- size x64 download
- color x64 download
- graphics x64 download
- gif x64 download
- panorama x64 download
- photoshop x64 download
- software x64 download
- jpeg x64 download
- utility x64 download
- photo x64 download
- plugin x64 download
- cover x64 download
- tool x64 download
- rgb x64 download
- png x64 download
- jpg x64 download
- pictures x64 download
- images x64 download
- vanderlee x64 download
- bmp x64 download
- photos x64 download
- vdl x64 download
- picture x64 download
- scanner x64 download
- screen x64 download
- video x64 download
- scan x64 download
- dust x64 download
GSA Image Analyser 4.5.5
Sponsored links:
license: Shareware ($332.00)
downloads: 244
size: 25.59 MB
updated: 2026-02-18
tags: Image analyser, Image analyzer, biometric recognition, cell count, object counting, image measurement, microscope analysis, image microscopy, particle counting
Buy Now
Add to Basket
GSA
The GSA Image Analyser is a program for the scientific evaluation of 2D images (image analysis). The possibilities of the program are varied and can be divided in three main groups; Object surface calculation, Object length calculation and Object counting. The surfaces of all recognised objects are automatically calculated. In addition, the surface calculation of single objects is possible. The program offers the possibility to calculate the relations of the ascertained surfaces to each other and to the whole image or background. The GSA Image Analyser has a set of functions which have been developed especially for the direct length calculation of very complex and very ramified objects. Such objects are for example plant roots. In addition to the direct length calculation, an indirect calculation with a grid intersection (developed by Tennant) is possible. For this function, the grid size can be freely defined. The automatic count function determines the number of all recognised objects and, in addition, offers the possibility to count overlapping objects apart. This separation can made over the object form, the object surface and over the object intensity. The grid intersection count function serves for the indirect object number regulation. Such procedures are described, e.g., by Buerker, Fuchs Rosenthal, Thoma, shilling, Tuerk. Beside the automatic count functions, the program has two manual count procedures included. One method marks the objects inside of the image and the other cuts the image into several smaller parts to make it easier for human eyes to follow many small objects. The GSA Image Analyser can read almost all known picture formats (JEPEG, GIF, TIFF, BMP, PNG). In addition, the program provides interfaces to scanners, microscopes and digital cameras (TWAIN) as well as to video cameras (Video grabber, TV cams). This program is designed to solve many problems. It has been used for counting cells and calculating the size of plant roots (biometry).
Homepage: GSA Image Analyser
OS: Windows 7 x32, Windows 7 x64, WinOther, Windows XP, Win2000, WinServer, Windows Vista, Windows Vista x64, Windows XP, Windows 8, Windows 10, Windows 11
Requirements: 128MB RAM
Add Your Review or 64-bit Compatibility Report
Top Other 64-bit downloads
World Tools 2.0.6
An Adobe InDesign to work on right-to-left languages and writing scripts
Shareware | $99.00
iWisdom 0.0.0+2107~ga0785ce1
An application which helps you store small bits of wisdom, such as quotations
Open Source
Topaz DeJPEG 4.1.0
Gives you the ability to improve the quality of your JPEG images
Trialware | $29.99
Topaz DeNoise 6.0.1
A Photoshop plugin that can help you remove digital image noise
Trialware | $79.99
Members area
Top 64-bit Downloads
-
Fluid Mask for Mac 3.3.14
x64 trialware download -
ICO file format x64 2.1f1
x64 open source download -
Archicad 64bit 27 B3001
x64 demo download -
Affinity Photo 2.5.3
x64 trialware download -
Portable MicroDicom x64 2024.2
x64 freeware download -
Adobe Photoshop Elements 2024.3
x64 trialware download -
ImageJ x64 1.54i
x64 freeware download -
Volocity 64bit 6.5.1
x64 demo download -
TopSpice 10.26a
x64 demo download -
Potrace for Windows (x64
bit) 1.16
x64 open source download
Top Downloads
-
CorelDRAW X5 2026 v27.0.0.121
trialware download -
Tracfoil 4.12.07
trialware download -
oCam 428.0
freeware download -
Gyazo 5.9.1
demo download -
CodeLoader 4.19.0
freeware download -
SeiSee 2.22.6
freeware download -
MarvinSketch 23.16.0
freeware download -
MapInfo Professional 17.0.4
trialware download -
World Tools 2.0.6
shareware download -
Texmod 0.9b
freeware download -
iWisdom 0.0.0+2107~ga0785ce1
open source download -
sigTOOL 0.95
open source download -
LTpowerCAD 2.7.2
freeware download -
nanoCAD 5.1.2524.2017
freeware download -
ImageConvertPro 2.01.07
shareware download